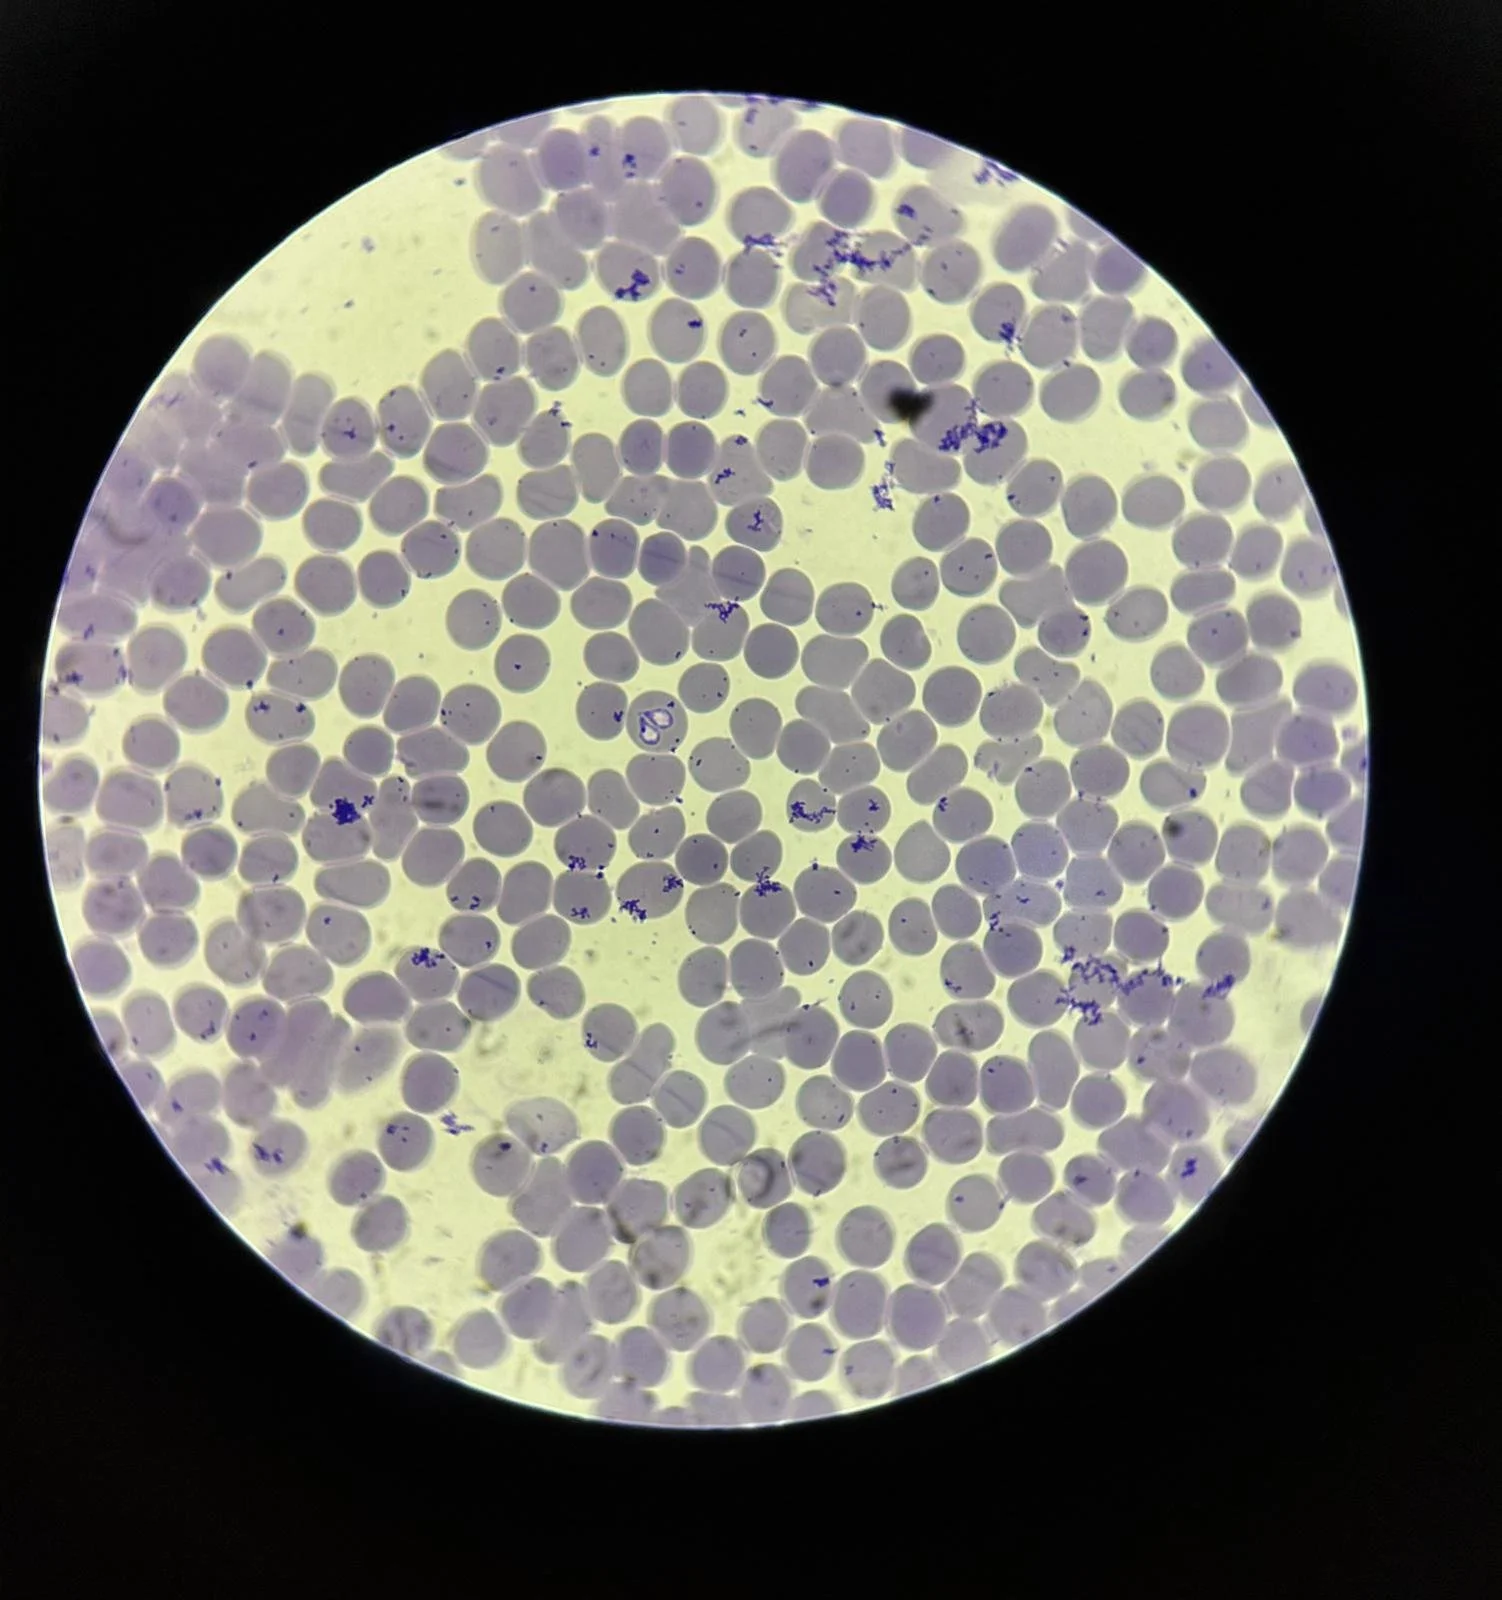
Babesioza la câini: o boală transmisă de căpușe&nbsp;care pune viața în pericol

Ce rase de câini și pisici sunt predispuse la probleme cardiace?
Patologiile cardiace nu apar doar la animalele în vârstă. În multe cazuri, ele au o componentă genetică, ceea ce înseamnă că anumite rase sunt mai predispuse la afecțiuni cardiace încă de la vârste fragede.
Pentru proprietari, această informație este esențială. Nu pentru a crea panică, ci pentru a ști când este momentul potrivit pentru monitorizare și controale regulate.

De ce se scarpină constant câinele sau pisica ta? Cauze frecvente și când să mergi la veterinar
Scărpinatul ocazional este normal. Însă dacă observi că animaluțul tău se scarpină constant, insistent sau chiar obsesiv, este un semnal clar că ceva nu este în regulă

Cum se tratează aritmiile și tulburările de ritm la câini și pisici?
Ritmul inimii influențează direct starea de bine a câinilor și pisicilor. O frecvență cardiacă prea rapidă, prea lentă sau neregulată poate trece uneori neobservată, mai ales în stadiile incipiente. Alteori, aceste modificări se manifestă prin semne care îi alarmează pe proprietari. În practica veterinară, aritmiile cer atenție, evaluare atentă și decizii adaptate fiecărui animal.

Alergie alimentară vs alergie la factori de mediu la câini și pisici: cum le diferențiezi corect?
Mâncărimea constantă, linsul excesiv sau infecțiile recurente ale pielii sunt printre cele mai frecvente motive pentru care un animal ajunge la medicul veterinar. În spatele acestor simptome, de foarte multe ori, se află o alergie. Dar nu toate alergiile sunt la fel.
Două dintre cele mai întâlnite tipurI, alergia alimentară și alergia de mediu (atopia), pot arăta aproape identic la exterior, dar necesită abordări complet diferite.

Ce cauzează insuficiența cardiacă la câini și cum o gestionează echipa Animal Care Center?
Totul despre insuficienta cardiaca la caini - cauze, simptome, tratament. Analize, diagnostic și îngrijire în Animal Care Center.

Când este recomandată ecografia toracică pentru câini și pisici
Sănătatea respiratorie și cardiacă a câinilor și pisicilor ridică adesea întrebări pentru proprietari, mai ales atunci când apar simptome care nu se observă ușor. Tusea persistentă, respirația accelerată, oboseala apărută brusc sau modificările de comportament pot avea cauze diverse, unele ușor de gestionat, altele care necesită investigații suplimentare. Ecografia toracică ajută medicul veterinar să vadă ce se întâmplă în interiorul cavității toracice și să ia decizii informate, adaptate fiecărui pacient.

Cum recunoști și tratezi piodermitele la animalele de companie
Cum recunosti piodermita la caini si pisici, ce semne trebuie sa urmaresti si ce pasi practici de tratament si preventie recomanda medicii Animal Care Center.
Babesioza la câini: o boală transmisă de căpușe care pune viața în pericol
Babesioza este una dintre cele mai frecvente și periculoase boli transmise de căpușe la câini. În fiecare sezon cald, medicii veterinari diagnostichează numeroase cazuri, unele ajungând în stare critică dacă tratamentul nu este început rapid. Boala evoluează rapid și afectează în special globulele roșii ale sângelui, ceea ce poate duce la anemie severă și complicații grave.

De ce este importantă monitorizarea ECG pentru animalele cu probleme cardiace?
Bolile cardiace la câini și pisici apar mai des decât par la prima vedere. Multe evoluează fără semne evidente, iar animalele își păstrează rutina zilnică chiar dacă inima lor întâmpină dificultăți. Monitorizarea ECG ajută medicii veterinari să observe ce se întâmplă cu ritmul cardiac și să ia decizii informate, adaptate fiecărui pacient. În clinicile PartnerVet, această investigație susține diagnosticul, urmărirea în timp și siguranța animalelor cu risc cardiac.

Radiografie veterinară: ce este, când se recomandă și de ce este esențială pentru un diagnostic corect
Radiologia este o parte esențială a medicinei veterinare moderne. Fie că este vorba despre un accident, o problemă digestivă, o durere apărută brusc sau o suspiciune de boală internă, radiografia ajută medicul să obțină rapid informații importante despre starea de sănătate a animăluțului tău.

